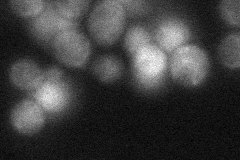
YJR103W
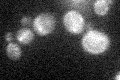
YJR103W

View description
Minor CTP synthase isozyme (see also URA7), catalyzes the ATP-dependent transfer of the amide nitrogen from glutamine to UTP, forming CTP, the final step in de novo biosynthesis of pyrimidines; involved in phospholipid biosynthesis
Localization:
Intensity:
Fold change:
Significance:
-
C’ GFP library in SD

below threshold17.24 -
N' NOP1pr-GFP in SD

ER,vacuole84.2522 -
N' TEF2pr-mCherry in SD

vacuole34.2027 -
N' NATIVEpr-GFP in SD
cytosol30.0458 -
N' TEF2pr-VC and Cyto-VN in SD

#N/A0 -
C’ GFP library in SD+DTT

cytosol16.340.94No -
C’ GFP library in SD+H2O2
cytosol17.281No -
C’ GFP library in Starvation Media

cytosol14.310.83No -
C’ GFP library on the background of Pup2-DaMP

below threshold -
C’ GFP library on the background of CCT mutant

below threshold17.84581.0346No
